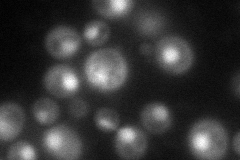
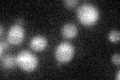
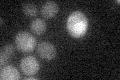

View description
Meiosis-specific DNA binding protein that displays Red1p dependent localization to the unsynapsed axial-lateral elements of the synaptonemal complex; required for homologous chromosome synapsis and chiasma formation
Localization:
Intensity:
Fold change:
Significance:
-
C’ GFP library in SD

below threshold18.02 -
N' NOP1pr-GFP in SD
nucleus85.2606 -
N' TEF2pr-mCherry in SD

nucleus0 -
N' NATIVEpr-GFP in SD

below threshold20.358 -
N' TEF2pr-VC and Cyto-VN in SD

cytosol36.3785 -
C’ GFP library in SD+DTT
cytosol16.20.89No -
C’ GFP library in SD+H2O2

cytosol17.480.96No -
C’ GFP library in Starvation Media
cytosol14.970.83No -
C’ GFP library on the background of Pup2-DaMP

below threshold -
C’ GFP library on the background of CCT mutant

below threshold18.2941.01486No
